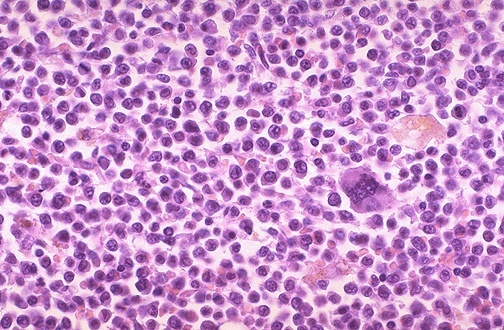

Acute Leukemia
Leukemogenic
Events
Differentiation Block
Cells are no longer able to develop beyond the blast stage.

Proliferation Advantage

Acute Leukemia
Pathophysiology
Acute Leukemia
WHO Classification
Myeloblasts
Morphology

Acute Leukemia
Immunohistochemical Evaluation
ALL “PAS”
AML is a MES

Acute Leukemia
Immunophenotyping
Based on flow cytometry:

Acute Myeloid Leukemia (AML)
Overview

Acute Myeloid Leukemia (AML)
FAB Classification
Based on morphology:
Know M3, M4, M5

Acute Myeloid Leukemia (AML)
WHO Classification
Based on recurrent genetic abnormalities, etiologies, and morphology:

Acute Myeloid Leukemia (AML)
Presenting Symptoms
Acute Myeloid Leukemia (AML)
Initial Work-up
Acute Myeloid Leukemia (AML)
Diagnostic Evaluation
Acute Myeloid Leukemia (AML)
Prognosis
Acute Promyelocytic Leukemia (APL)
Characteristics

Monocytic Leukemias
Characteristics

Risk-Adapted Treatment
Principles

Multi-Agent Chemotherapy
Adverse Effects
Acute Lymphoblastic Leukemia (ALL)
Characteristics

Acute Lymphoblastic Leukemia (ALL)
FAB Classification
Based on morphology.

Acute Lymphoblastic Leukemia (ALL)
WHO Classification
Genetic/molecular based system.

B-cell Acute Lymphoblastic Leukemia (B-ALL)
Translocations
Fusions w/ chimeric protein expression: